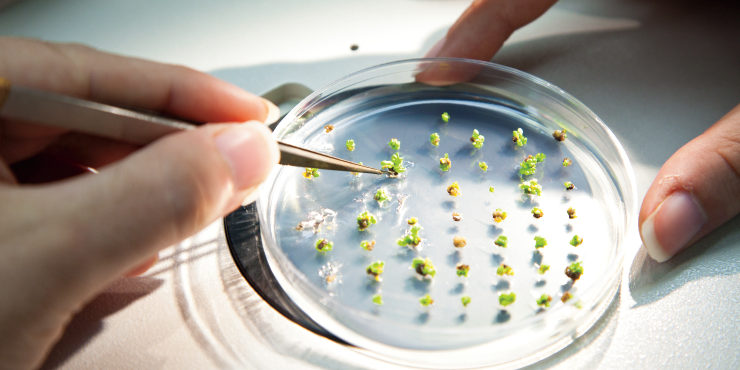

OWNER: Bayer Corp Science
LOCATION: Phoenix, Arizona
DESCRIPTION: Construction of the Bayer Corp Science facility consisted of removing existing on-site modular facilities in two phases: demo/construction and parking lot/landscaping. Interior improvements included the creation of office spaces, a breakroom, locker facilities and a fully functional lab that tests and certifies cotton seed research and sales. Upon completion of the office and lab space, a 30-car parking lot and complimenting landscaping was initiated.